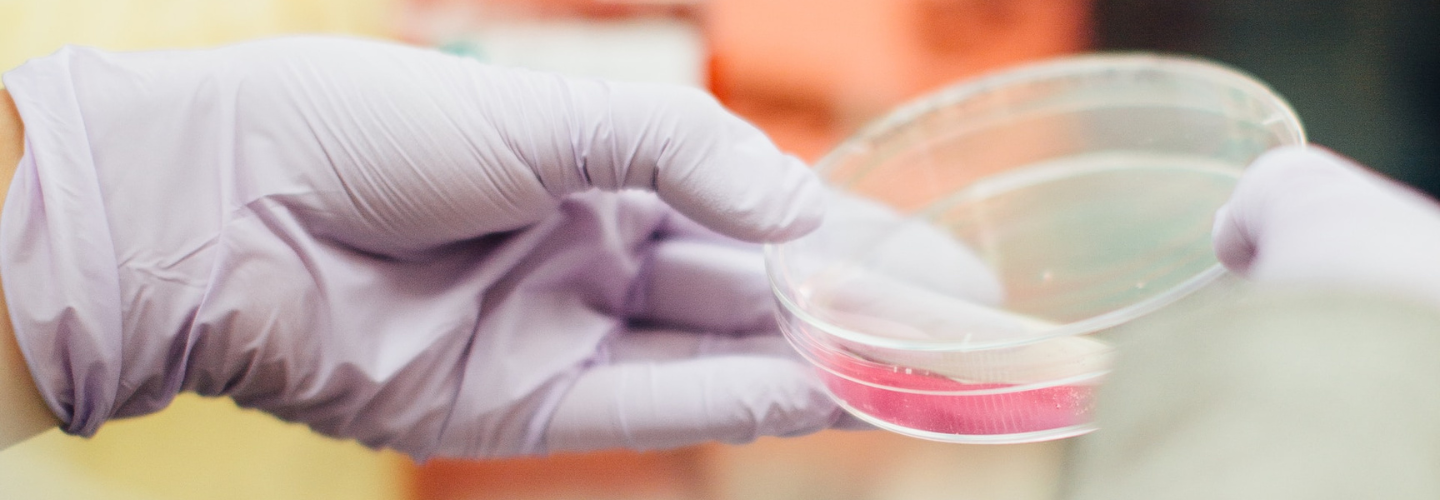

En el apartado de Ciencia de El País Miguel Jiménez publica la noticia que hace referencia a la aprobación por la FDA del tratamiento de pacientes con anemia de células falciformes mediante edición genética CRISPR. La aprobación de esta modalidad terapéutica basada en la edición del genoma ofrece la posibilidad de aplicar tratamientos específicos en enfermedades “raras” para las que todavía no se dispone de opciones terapéuticas o éstas son muy limitadas.
La existencia de una mutación genética que altera la formación de la hemoglobina es la causa de esta enfermedad y mediante la utilización de la tecnología de edición genética CRISPR es posible evitar los efectos de esta mutación y sus consecuencias en la formación de las proteínas que conforman la hemoglobina. La aplicación de este tratamiento es compleja, no está exenta de dificultades, y requiere disponer de medios y recursos adecuados.
La anemia falciforme se debe a mutaciones en genes que codifican los componentes estructurales de la hemoglobina adulta, pero no en los genes que codifican la estructura de la hemoglobina fetal. Tras la extracción de células madre sanguíneas de la médula ósea, se aíslan y, mediante la utilización de “tijeras” moleculares, se edita el genoma suprimiendo la zona en la que está situado el gen BCL11A que impide la producción de hemoglobina fetal tras el nacimiento, es decir se evita el “silenciamiento” del gen de la hemoglobina fetal. Para poder sustituir las células sanguíneas del paciente por las células modificadas, es necesaria la aplicación de tratamiento quimioterápico y, una vez suprimidas las células de la médula ósea, la trasfusión de las células madre modificadas. Éstas desde la médula ósea se multiplican y conducen a la formación de hemoglobina fetal y a la producción de glóbulos rojos que, al contener esta hemoglobina, trasportan adecuadamente el oxígeno y además son menos rígidas, adquieren su forma habitual y no la de una media luna u hoz, y no provocan los fenómenos trombóticos, las alteraciones en el desarrollo y el acortamiento de la vida que caracterizan a la anemia de células falciformes.
En la aprobación de este tratamiento por la FDA se ha tenido en cuenta la información aportada por un ensayo en pacientes adultos y adolescentes, en el que se han analizado la seguridad y eficacia del tratamiento. Tal como se señala en el artículo, los pacientes tenían antecedentes de al menos dos episodios graves de incidentes vaso-oclusivos. El resultado primario de eficacia fue la ausencia de episodios graves de ese tipo durante al menos 12 meses consecutivos durante el periodo de seguimiento de 24 meses. Fueron tratados 44 pacientes y, de los 31 pacientes con tiempo de seguimiento suficiente para ser evaluables, 29 (93,5%) lograron el objetivo primario. Todos los pacientes tratados consiguieron un injerto satisfactorio y ninguno experimentó fracaso o rechazo del injerto. El artículo finaliza señalando los comentarios de la doctora Nicole Verdun, directora de la Oficina de Productos Terapéuticos del Centro de Evaluación e Investigación Biológica de la FDA “La terapia génica encierra la promesa de ofrecer tratamientos más específicos y eficaces, especialmente para las personas con enfermedades raras en las que las opciones terapéuticas actuales son limitadas”, y las de Peter Marks, director del Centro de Evaluación e Investigación Biológica de la FDA. “Estas aprobaciones representan un importante avance médico con el uso de terapias génicas celulares innovadoras para tratar enfermedades potencialmente devastadoras y mejorar la salud pública”.
Newsletter
Contacto